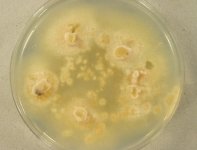

Search Details
| UAMH Number: | 7783 |
|---|---|
| Species Name: | Tulasnella calendulina |
| Type: | |
| Synonyms: | Epulorhiza calendulina |
| Taxonomy: | FUNGI Basidiomycota, Agaricomycetes, Cantharellales, Tulasnellaceae |
| Strain History: | C. Zelmer -> Currah, R.S. (Z10-orh-2a(1)) -> UAMH |
| Substrate: | pelotons in root cortical cells of small round-leaf orchid Amerorchis rotundifolia (Orchidaceae) | Location: | CANADA Alberta, Calahoo (GEO: 53.716,-113.916) |
| Isolator: | C. Zelmer |
| Isolation Date: | 1991-07-07 |
| Date Received: | 1994-12-21 |
| Characters: | MOLECULAR SYSTEMATICS orchid mycorrhizal fungi - Lievens B, van Kerckhove S, Juste A, Cammue BP, Honnay O, Jacquemyn H, J Microbiol Methods 80:76-85, 2010 // MYCORRHIZAE with Amerorchis rotundifolia - Zelmer & Currah, Can. J. Bot. 73:1981-1985, 1995 // MYCORRHIZAE with orchid Amerorchis rotundifolia - (Click for publications citing UAMH 7783) |
| Compounds: | |
| Cross Reference: | |
| Collections: | Living Strains; Dried Herbarium Material |
| Pathogenic Potential: | Human: no | Animal: no | Plant: yes |
| Biosafety Risk Group: | RG1 (check the PHAC ePATHogen Risk Group Database for updates) |
| Regulatory Requirements: | No restrictions for Canadian requesters. International requesters must provide all legally required importation documentation prior to shipment. Plant pathogenicity status may be verified by using the USDA Agricultural Research Service (ARS) Fungal Database |
| MycoBank ID: | 832428 |
| Sequences: | >UAMH07783_KF266997 GAGGCAATAACAGGTCTGTGATGCCCTTAGATGTTCTGGGCCGCACGCGCGCTACACTGACAGGGCCAGCGAGTTTTTTTCCTTGGCAGAGATGTCCGGGTAATCTTGTGAAACCCTGTCGTGCTGGGGATAGAGCATTGCAATTATTGCTCTTCAACGAGGAATGCCTAGTAAACGTGAGTCATCAGCTCGCGTTGATTACGTCCCTGCCCTTTGTACACACCGCCCGTCGCTACTACCGATTGAATGGCTTAGTGAGGCCTTCGGATTGGCTTCGGGGATCCGGAAACGGAACCCTGTCGCTAAGAAGTTGGTCAAACTCGGCCATTTAGAGGAAGT >UAMH07783_KF267034 AACTCGGCCATTTAGAGGAAGTAAAAGTCGTAACAAGGTTTCCGTAGGTGAACCTGCGGAAGGATCATTAAAGATGTTCAACGGATGTGCTGGCGTCTAACACCGCATGTGCACTCCATAACACATTTACACACCTGTGAACCTCGGACCGCGTTGTCCTCTCTAGGGATGGCGTGCGTTCAAACCTTTGCAAAACCCTTTGAAACAAGCTCTGGAAAGTTGACGCTATAGTTAAAACAACCATCAGCAACGGATCTCTTGGCATTCCAATCGATGAAGAACGCAGC >UAMH07783_KF267071 GTGAATCATCGAATCTTTGAACGCACCTTGCGCCCTCTGGTATTCCGGAGGGCATGCCCGGTTGAGTGTCATGAATATCTCAACCCCAACGCTTTGTTTGAAAGTCCCTTGACGTGCCGGCTGGCCTAGCGAGGCCGCCGTAGCATTCCTTGCGACTGAAGCGCTGGGGCTTGGACTTGAGCTCTGTTGGCCTTTGTGTCGACTGGCTTGAAATTGATCAGCGATGCGCGATCCCTTGGGTCCATCTCGGCGTGATAAGTTGATCGTCGCAAAGGACTTCCTTGGGTGTGGCTTGCTTCTAATTGTCTTAGGACAGCTTTTGACGTTTACACCTCAACTCGGGTAGGACTACCCGCTGAACTTAAGCATATCAATAAGCGAAGGAAAAGA >UAMH07783_KF267108 AACAAGGATTCCCCTAGTAACGGCGAGTGAAGCGGGAAGAGCTCAAATTTTAAATCTGGCGGTCTCCGGCCGTCCGAGTTGTAAATTATAGAAGCGTTATCTGTGCCGGACCTGCCATAAGTTGTCTTGAATGATATATCAGAGAGGGTGAGAATCCCGTGCTTTTGCAGGATCACCGGGGCTATATGTTGCGCTCTCAACGAGTCGAGTTGTTTGTGATTGCAGCTCCAAATGGGAGGTAAATTCCTTCTAAAGCTAAATATCTTGGAATGACCGATAGCGAACAAGTACCGTGAGGGAAAGATGAAAAGAACTTTGGAAAGAGAGTTAAACAGTACGTGAAATTGTTAAAAGGGAAAC |
IMAGES: